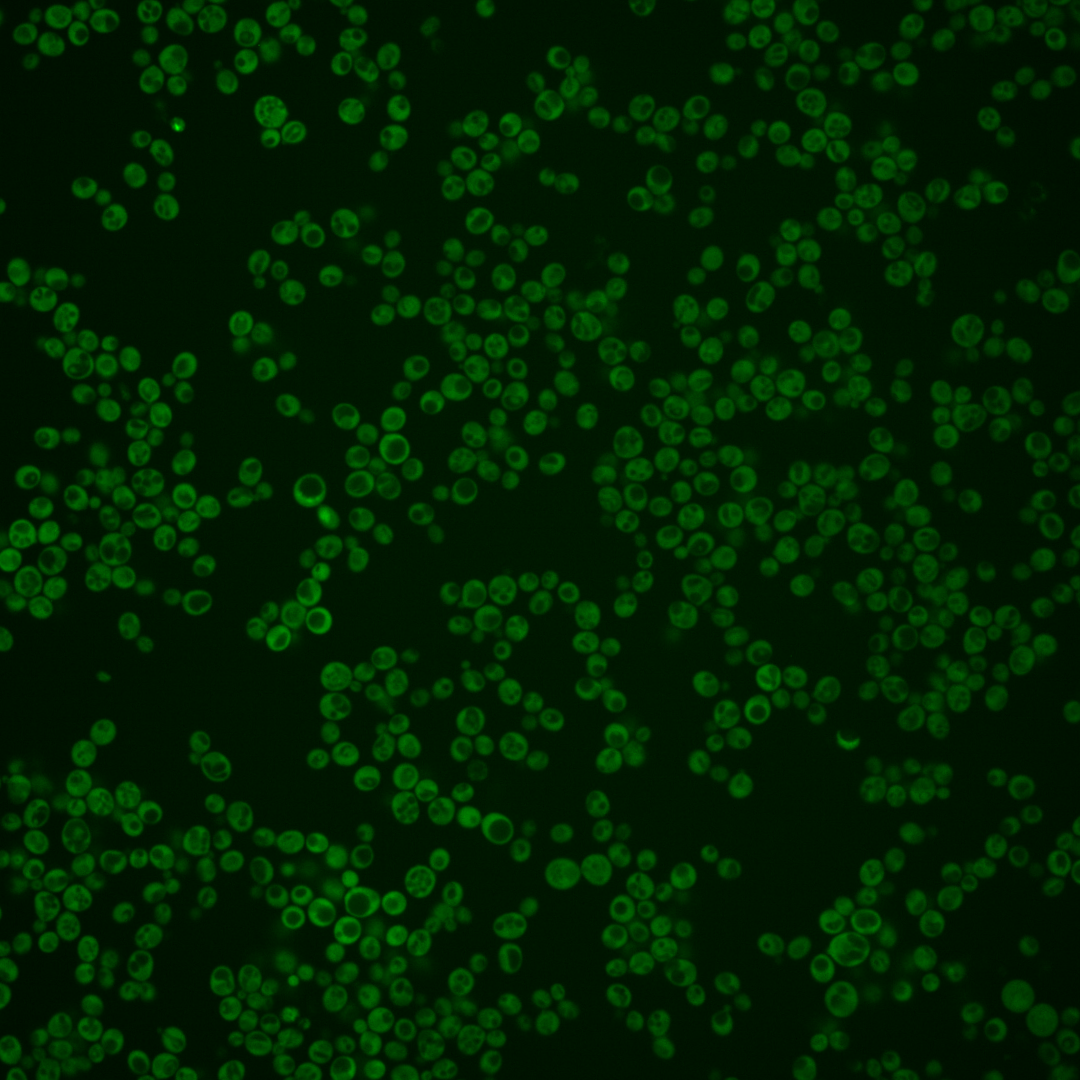
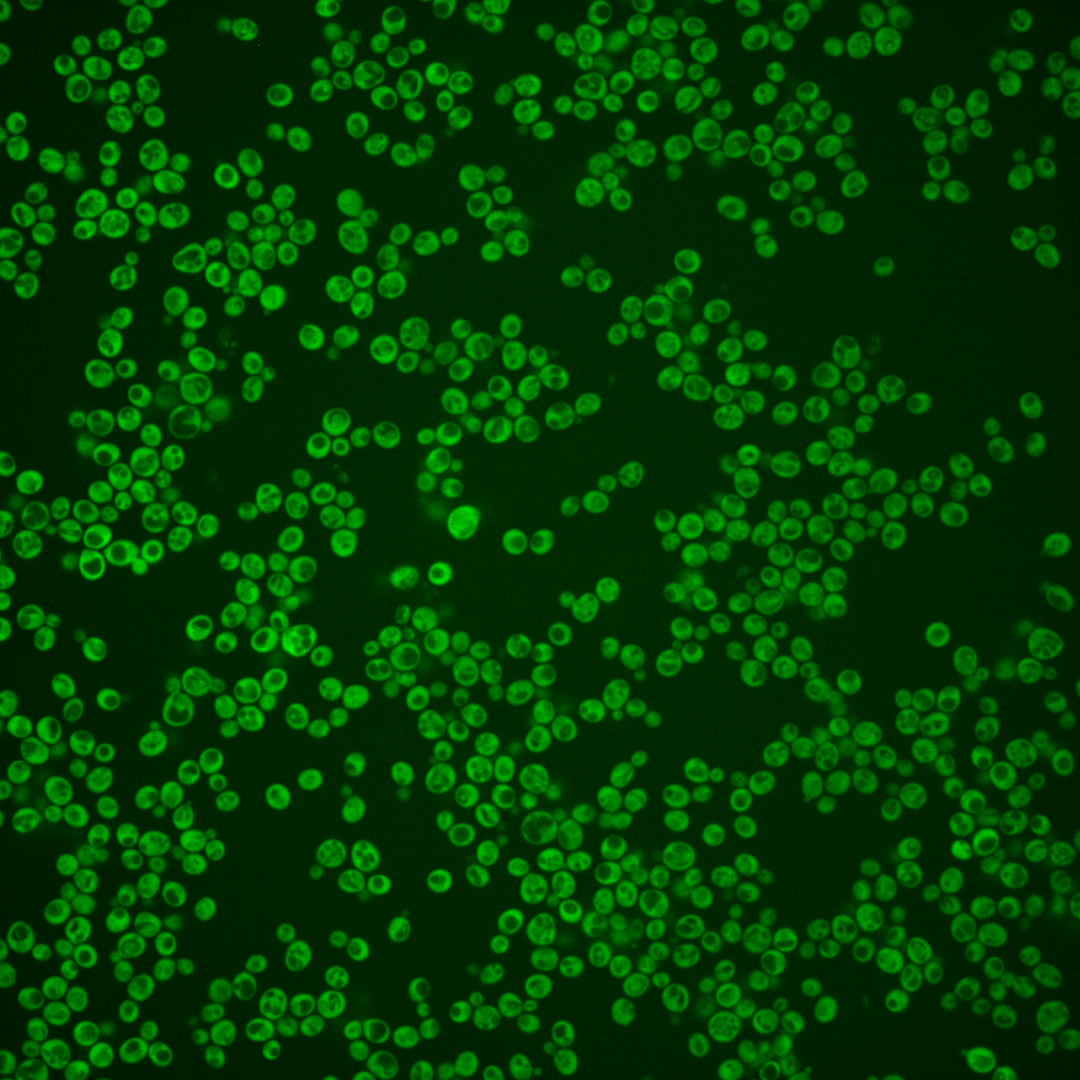
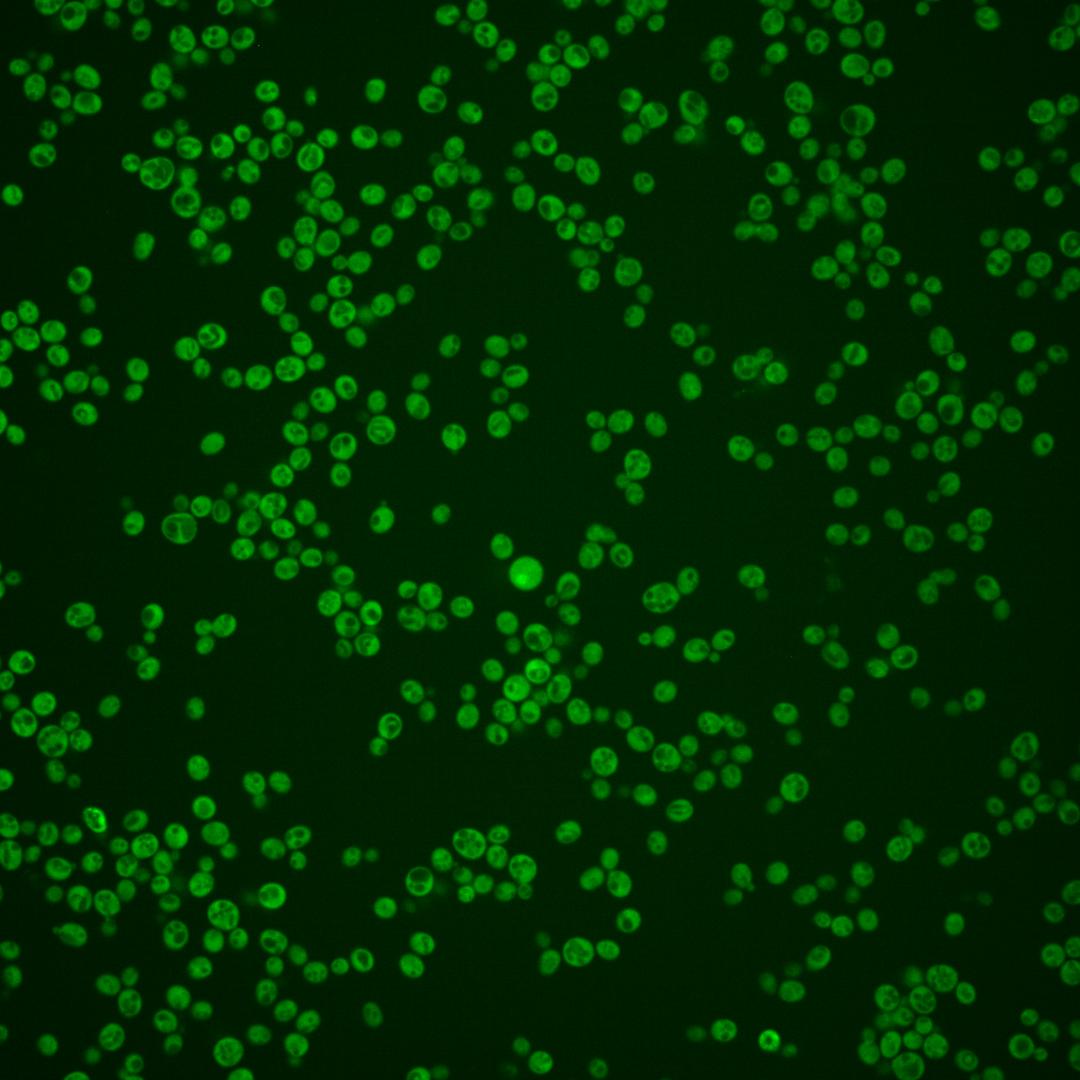
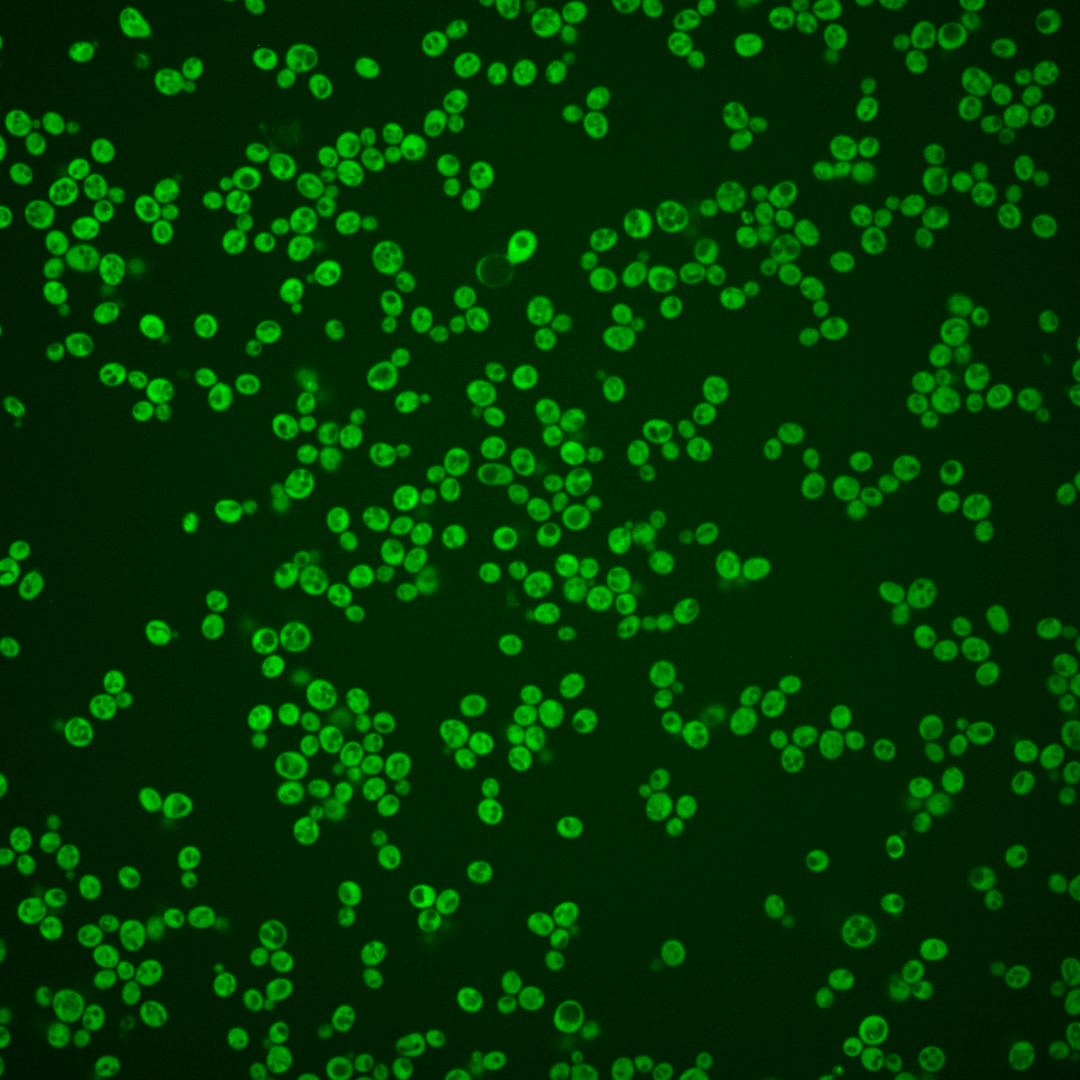
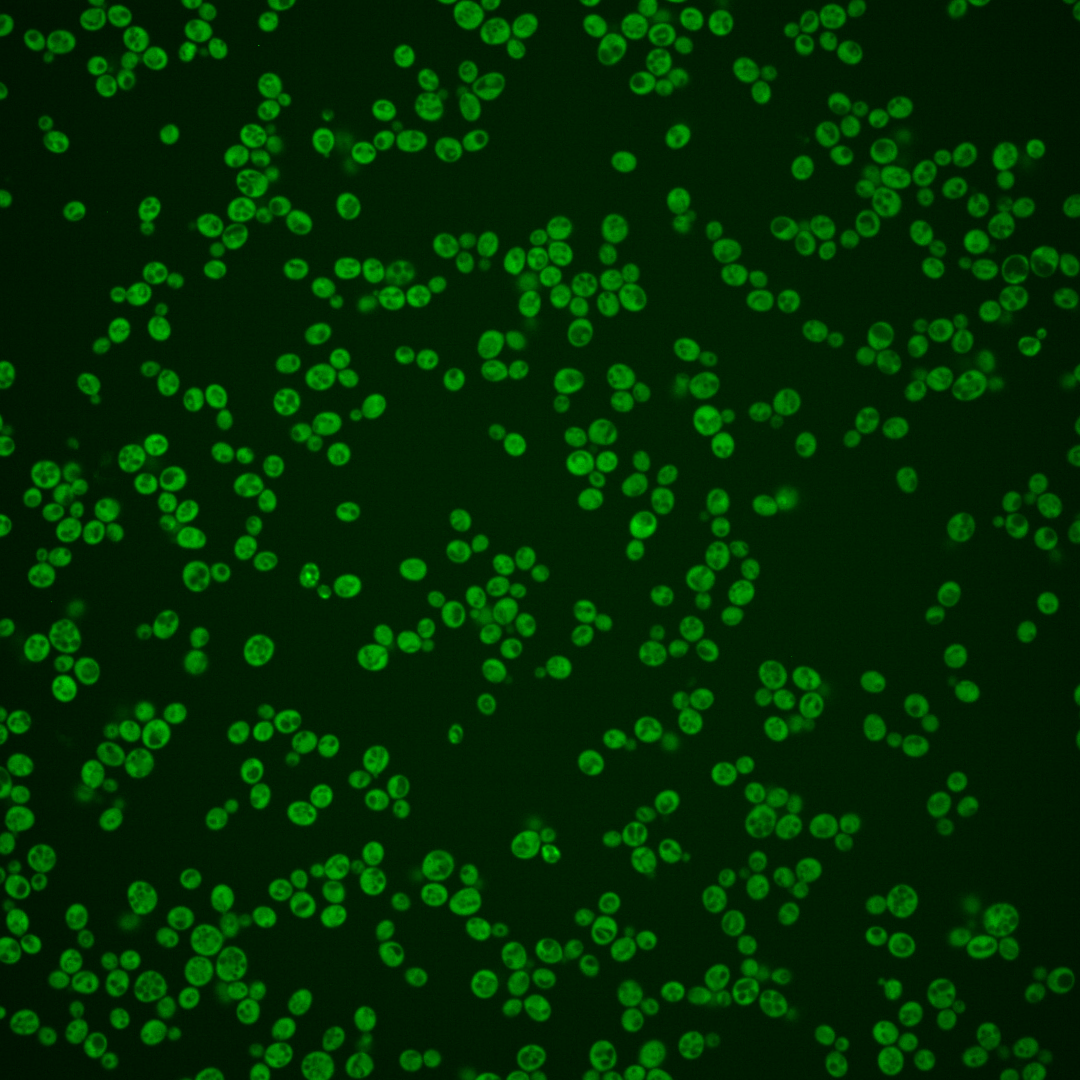

| Standard name | |
|---|---|
| Human Ortholog | |
| Description | Cytoplasmic protein required for replication of Brome mosaic virus; S. cerevisiae is a model system for studying replication of positive-strand RNA viruses in their natural hosts |
Micrographs




















































































Sub-cellular Localization
Yeast GFP Assignment
Protein Abundance
Localization Change
External localization resources
| ensLOC | DeepLoc | |||||||||||||||||||||||
|---|---|---|---|---|---|---|---|---|---|---|---|---|---|---|---|---|---|---|---|---|---|---|---|---|
| Localization | WT1 | WT2 | WT3 | RAP60 | RAP140 | RAP220 | RAP300 | RAP380 | RAP460 | RAP540 | RAP620 | RAP700 | HU80 | HU120 | HU160 | rpd3Δ_1 | rpd3Δ_2 | rpd3Δ_3 | WT1 | WT2 | WT3 | AF100 | AF140 | AF180 |
| Cortical Patches | 0 | 0 | 0 | 0 | 1 | 2 | 5 | 10 | 6 | 3 | 7 | 9 | 0 | 1 | 0 | 0 | 0 | 0 | 0 | 2 | 1 | 0 | 1 | 1 |
| Bud | 0 | 3 | 0 | 0 | 1 | 0 | 2 | 2 | 3 | 1 | 4 | 2 | 1 | 0 | 0 | 0 | 0 | 0 | 0 | 0 | 0 | 0 | 0 | 0 |
| Bud Neck | 0 | 0 | 0 | 0 | 0 | 0 | 0 | 0 | 0 | 0 | 0 | 0 | 0 | 0 | 0 | 0 | 0 | 0 | 1 | 1 | 1 | 0 | 1 | 0 |
| Bud Site | 0 | 0 | 0 | 0 | 0 | 0 | 0 | 0 | 0 | 0 | 0 | 0 | 0 | 0 | 0 | 0 | 0 | 0 | – | – | – | – | – | – |
| Cell Periphery | 3 | 4 | 10 | 10 | 17 | 15 | 6 | 7 | 12 | 12 | 14 | 16 | 11 | 13 | 13 | 32 | 30 | 28 | 0 | 0 | 0 | 0 | 0 | 0 |
| Cytoplasm | 313 | 330 | 169 | 209 | 257 | 206 | 234 | 243 | 267 | 189 | 150 | 148 | 306 | 396 | 410 | 434 | 338 | 351 | 308 | 319 | 152 | 139 | 282 | 301 |
| Endoplasmic Reticulum | 1 | 7 | 4 | 8 | 10 | 11 | 18 | 15 | 16 | 16 | 12 | 3 | 1 | 7 | 5 | 11 | 12 | 10 | 1 | 6 | 10 | 1 | 2 | 8 |
| Endosome | 0 | 0 | 0 | 0 | 0 | 0 | 0 | 0 | 1 | 0 | 0 | 1 | 0 | 1 | 1 | 4 | 0 | 1 | 1 | 5 | 1 | 0 | 1 | 2 |
| Golgi | 0 | 2 | 1 | 0 | 1 | 0 | 2 | 0 | 1 | 0 | 0 | 0 | 0 | 0 | 0 | 3 | 3 | 1 | 0 | 1 | 1 | 0 | 0 | 0 |
| Mitochondria | 1 | 2 | 0 | 0 | 4 | 18 | 28 | 28 | 61 | 45 | 109 | 68 | 0 | 0 | 0 | 8 | 2 | 4 | 1 | 3 | 1 | 1 | 1 | 2 |
| Nucleus | 4 | 0 | 1 | 0 | 2 | 0 | 3 | 3 | 1 | 3 | 1 | 0 | 1 | 2 | 2 | 16 | 7 | 10 | 1 | 2 | 0 | 0 | 3 | 0 |
| Nuclear Periphery | 0 | 0 | 0 | 0 | 0 | 0 | 0 | 0 | 1 | 0 | 1 | 0 | 0 | 0 | 0 | 0 | 1 | 0 | 0 | 0 | 0 | 0 | 0 | 1 |
| Nucleolus | 0 | 0 | 0 | 0 | 0 | 0 | 0 | 0 | 1 | 0 | 0 | 0 | 0 | 0 | 0 | 0 | 0 | 1 | 0 | 0 | 0 | 0 | 0 | 0 |
| Peroxisomes | 0 | 0 | 0 | 0 | 0 | 0 | 0 | 0 | 0 | 0 | 0 | 1 | 0 | 0 | 0 | 0 | 0 | 0 | 0 | 0 | 0 | 0 | 0 | 0 |
| SpindlePole | 0 | 0 | 0 | 0 | 0 | 0 | 0 | 0 | 0 | 0 | 0 | 0 | 0 | 0 | 0 | 0 | 0 | 0 | 0 | 0 | 0 | 0 | 0 | 0 |
| Vac/Vac Membrane | 0 | 5 | 2 | 1 | 9 | 7 | 5 | 10 | 19 | 14 | 8 | 14 | 1 | 0 | 1 | 36 | 36 | 35 | 2 | 5 | 2 | 1 | 2 | 3 |
| Unique Cell Count | 316 | 343 | 177 | 220 | 282 | 240 | 277 | 297 | 354 | 263 | 246 | 225 | 308 | 404 | 416 | 497 | 386 | 399 | 319 | 353 | 179 | 146 | 303 | 328 |
| Labelled Cell Count | 322 | 353 | 187 | 228 | 302 | 259 | 303 | 318 | 389 | 283 | 306 | 262 | 321 | 420 | 432 | 544 | 429 | 441 | 319 | 353 | 179 | 146 | 303 | 328 |
Yeast GFP Assignment
Protein Abundance
| Screen | WT1 | WT2 | WT3 | RAP60 | RAP140 | RAP220 | RAP300 | RAP380 | RAP460 | RAP540 | RAP620 | RAP700 | HU80 | HU120 | HU160 | rpd3Δ_1 | rpd3Δ_2 | rpd3Δ_3 | AF100 | AF140 | AF180 |
|---|---|---|---|---|---|---|---|---|---|---|---|---|---|---|---|---|---|---|---|---|---|
| Mean Cell GFP Intensity (1e-4) | 9.8 | 11.5 | 11.2 | 10.7 | 10.1 | 9.1 | 8.4 | 8.3 | 7.5 | 7.4 | 7.0 | 7.5 | 11.7 | 11.8 | 11.2 | 12.4 | 12.7 | 12.0 | 11.3 | 11.9 | 11.8 |
| Std Deviation (1e-4) | 1.4 | 2.0 | 1.5 | 1.3 | 1.5 | 1.6 | 1.3 | 1.6 | 1.4 | 1.4 | 1.3 | 1.4 | 1.5 | 1.6 | 1.3 | 2.2 | 2.2 | 2.3 | 2.0 | 2.2 | 1.9 |
| Intensity Change (Log2) | – | – | – | -0.07 | -0.15 | -0.31 | -0.41 | -0.43 | -0.58 | -0.6 | -0.67 | -0.58 | 0.06 | 0.08 | 0.01 | 0.14 | 0.18 | 0.1 | 0.01 | 0.09 | 0.08 |
Localization Change
| Localization | RAP60 | RAP140 | RAP220 | RAP300 | RAP380 | RAP460 | RAP540 | RAP620 | RAP700 | HU80 | HU120 | HU160 | rpd3Δ_1 | rpd3Δ_2 | rpd3Δ_3 |
|---|---|---|---|---|---|---|---|---|---|---|---|---|---|---|---|
| Cortical Patches | 0 | 0 | 0 | 0 | 0 | 0 | 0 | 0 | 0 | 0 | 0 | 0 | 0 | 0 | 0 |
| Bud | 0 | 0 | 0 | 0 | 0 | 0 | 0 | 0 | 0 | 0 | 0 | 0 | 0 | 0 | 0 |
| Bud Neck | 0 | 0 | 0 | 0 | 0 | 0 | 0 | 0 | 0 | 0 | 0 | 0 | 0 | 0 | 0 |
| Bud Site | 0 | 0 | 0 | 0 | 0 | 0 | 0 | 0 | 0 | 0 | 0 | 0 | 0 | 0 | 0 |
| Cell Periphery | -0.5 | 0.2 | 0.3 | -2.0 | -1.9 | -1.2 | -0.5 | 0 | 0.6 | -1.1 | -1.4 | -1.5 | 0.4 | 0.9 | 0.6 |
| Cytoplasm | -0.2 | -1.8 | -3.2 | -3.6 | -4.3 | -5.7 | -6.2 | -8.1 | -7.2 | 2.9 | 1.7 | 2.3 | -3.0 | -2.9 | -2.8 |
| Endoplasmic Reticulum | 0.8 | 0.8 | 1.3 | 2.1 | 1.5 | 1.3 | 1.9 | 1.4 | 0 | 0 | 0 | 0 | 0 | 0.6 | 0 |
| Endosome | 0 | 0 | 0 | 0 | 0 | 0 | 0 | 0 | 0 | 0 | 0 | 0 | 0 | 0 | 0 |
| Golgi | 0 | 0 | 0 | 0 | 0 | 0 | 0 | 0 | 0 | 0 | 0 | 0 | 0 | 0 | 0 |
| Mitochondria | 0 | 0 | 3.7 | 4.4 | 4.2 | 5.9 | 5.8 | 10.3 | 8.0 | 0 | 0 | 0 | 0 | 0 | 0 |
| Nucleus | 0 | 0 | 0 | 0 | 0 | 0 | 0 | 0 | 0 | 0 | 0 | 0 | 0 | 0 | 0 |
| Nuclear Periphery | 0 | 0 | 0 | 0 | 0 | 0 | 0 | 0 | 0 | 0 | 0 | 0 | 0 | 0 | 0 |
| Nucleolus | 0 | 0 | 0 | 0 | 0 | 0 | 0 | 0 | 0 | 0 | 0 | 0 | 0 | 0 | 0 |
| Peroxisomes | 0 | 0 | 0 | 0 | 0 | 0 | 0 | 0 | 0 | 0 | 0 | 0 | 0 | 0 | 0 |
| SpindlePole | 0 | 0 | 0 | 0 | 0 | 0 | 0 | 0 | 0 | 0 | 0 | 0 | 0 | 0 | 0 |
| Vacuole | 0 | 0 | 0 | 0 | 0 | 2.4 | 2.3 | 0 | 2.6 | 0 | 0 | 0 | 3.0 | 3.6 | 3.5 |
External localization resources
Images






























Protein Concentration and Protein Localization Data
| R1 | R2 | R3 | ||||||||||||||||
|---|---|---|---|---|---|---|---|---|---|---|---|---|---|---|---|---|---|---|
| G1 Pre-START | G1 Post-START | S/G2 | Metaphase | Anaphase | Telophase | G1 Pre-START | G1 Post-START | S/G2 | Metaphase | Anaphase | Telophase | G1 Pre-START | G1 Post-START | S/G2 | Metaphase | Anaphase | Telophase | |
| Concentration | 4.4546 | 6.1677 | 5.7663 | 4.5409 | 4.9681 | 5.8754 | 4.7676 | 7.442 | 6.4123 | 5.448 | 6.1523 | 6.5614 | 6.3785 | 9.3183 | 7.9126 | 7.7636 | 7.8266 | 8.0417 |
| Actin | 0.02 | 0.0007 | 0.0036 | 0.0967 | 0.0381 | 0.0105 | 0.0039 | 0.001 | 0.0038 | 0.0106 | 0.001 | 0.0032 | 0.0072 | 0.0001 | 0.011 | 0 | 0.0136 | 0.0013 |
| Bud | 0.0021 | 0.0012 | 0.0007 | 0.0022 | 0.0026 | 0.0005 | 0.0053 | 0.0076 | 0.0037 | 0.0099 | 0.0045 | 0.0023 | 0.0005 | 0.0002 | 0.0003 | 0.0003 | 0.0009 | 0.0002 |
| Bud Neck | 0.003 | 0.004 | 0.0005 | 0.0027 | 0.001 | 0.0022 | 0.0019 | 0.0002 | 0.001 | 0.0005 | 0.0007 | 0.003 | 0.0009 | 0.0002 | 0.0005 | 0.0005 | 0.0008 | 0.0007 |
| Bud Periphery | 0.0009 | 0.0005 | 0.0004 | 0.0027 | 0.0043 | 0.0007 | 0.0021 | 0.0018 | 0.0021 | 0.0062 | 0.0015 | 0.0011 | 0.0004 | 0 | 0.0002 | 0.0001 | 0.0003 | 0.0001 |
| Bud Site | 0.0049 | 0.0105 | 0.0009 | 0.005 | 0.0035 | 0.0024 | 0.0022 | 0.0051 | 0.0053 | 0.0018 | 0.0014 | 0.0022 | 0.002 | 0.0005 | 0.0079 | 0.0003 | 0.0005 | 0.0001 |
| Cell Periphery | 0.0004 | 0.0006 | 0.0003 | 0.0006 | 0.0003 | 0.0002 | 0.0004 | 0.0002 | 0.0002 | 0.0002 | 0.0001 | 0.0001 | 0.0003 | 0.0001 | 0.0003 | 0.0001 | 0.0001 | 0.0001 |
| Cytoplasm | 0.766 | 0.897 | 0.9003 | 0.6211 | 0.6757 | 0.8731 | 0.8094 | 0.9493 | 0.8946 | 0.7868 | 0.8451 | 0.8902 | 0.798 | 0.9788 | 0.9029 | 0.9262 | 0.9016 | 0.9447 |
| Cytoplasmic Foci | 0.0445 | 0.0108 | 0.0116 | 0.0454 | 0.0562 | 0.0125 | 0.0281 | 0.0095 | 0.0231 | 0.0297 | 0.023 | 0.0197 | 0.0284 | 0.0043 | 0.0087 | 0.0066 | 0.012 | 0.0078 |
| Eisosomes | 0.0001 | 0 | 0.0001 | 0.0002 | 0.0001 | 0.0001 | 0 | 0 | 0 | 0.0001 | 0 | 0 | 0.0002 | 0 | 0.0001 | 0 | 0.0001 | 0 |
| Endoplasmic Reticulum | 0.0215 | 0.0035 | 0.0091 | 0.0104 | 0.0142 | 0.0373 | 0.0394 | 0.0021 | 0.0049 | 0.0186 | 0.0034 | 0.0119 | 0.0546 | 0.0044 | 0.0162 | 0.0112 | 0.0164 | 0.0145 |
| Endosome | 0.0451 | 0.0167 | 0.0252 | 0.0842 | 0.069 | 0.036 | 0.0431 | 0.0088 | 0.0248 | 0.0548 | 0.0454 | 0.032 | 0.044 | 0.0056 | 0.0205 | 0.0235 | 0.0315 | 0.0123 |
| Golgi | 0.0156 | 0.0052 | 0.0047 | 0.043 | 0.0234 | 0.0055 | 0.0084 | 0.0018 | 0.004 | 0.0114 | 0.0088 | 0.0075 | 0.008 | 0.0005 | 0.005 | 0.0002 | 0.0041 | 0.0024 |
| Lipid Particles | 0.02 | 0.0002 | 0.0007 | 0.0067 | 0.0035 | 0.0006 | 0.0027 | 0.0004 | 0.0028 | 0.004 | 0.0003 | 0.0008 | 0.011 | 0 | 0.0039 | 0 | 0.002 | 0.0055 |
| Mitochondria | 0.0091 | 0.0016 | 0.0208 | 0.0332 | 0.0612 | 0.0033 | 0.0146 | 0.0024 | 0.0041 | 0.0258 | 0.0409 | 0.0109 | 0.0076 | 0.0003 | 0.0119 | 0.0001 | 0.0016 | 0.0019 |
| None | 0.0067 | 0.0342 | 0.0098 | 0.0136 | 0.0027 | 0.0022 | 0.0068 | 0.0039 | 0.0033 | 0.0018 | 0.014 | 0.0038 | 0.005 | 0.0009 | 0.0014 | 0.0007 | 0.0026 | 0.0015 |
| Nuclear Periphery | 0.0028 | 0.001 | 0.0016 | 0.0014 | 0.0025 | 0.0047 | 0.0087 | 0.0004 | 0.002 | 0.0017 | 0.0007 | 0.0007 | 0.0066 | 0.0004 | 0.0009 | 0.001 | 0.0018 | 0.001 |
| Nucleolus | 0.0053 | 0.0011 | 0 | 0.0033 | 0.0002 | 0.0002 | 0.0007 | 0.0002 | 0.0003 | 0.0001 | 0.0001 | 0.0002 | 0.0002 | 0 | 0.0001 | 0 | 0.0001 | 0.0001 |
| Nucleus | 0.0035 | 0.0023 | 0.0013 | 0.0036 | 0.0018 | 0.0022 | 0.0053 | 0.0008 | 0.0048 | 0.0014 | 0.0013 | 0.0013 | 0.0018 | 0.0008 | 0.0009 | 0.0014 | 0.0016 | 0.0008 |
| Peroxisomes | 0.0082 | 0.0002 | 0.0003 | 0.0064 | 0.0102 | 0.0004 | 0.0033 | 0.001 | 0.0062 | 0.0163 | 0.0007 | 0.0009 | 0.0053 | 0 | 0.0022 | 0 | 0.0008 | 0.002 |
| Punctate Nuclear | 0.0128 | 0.0007 | 0.0005 | 0.0029 | 0.0118 | 0.001 | 0.001 | 0.0003 | 0.0009 | 0.0004 | 0.001 | 0.0034 | 0.0018 | 0 | 0.0002 | 0.0001 | 0.0015 | 0.0007 |
| Vacuole | 0.0061 | 0.0067 | 0.0064 | 0.0116 | 0.009 | 0.0031 | 0.0103 | 0.0027 | 0.007 | 0.0144 | 0.0049 | 0.0037 | 0.0121 | 0.0025 | 0.0041 | 0.0247 | 0.0052 | 0.0019 |
| Vacuole Periphery | 0.0015 | 0.0013 | 0.0011 | 0.0033 | 0.0087 | 0.0014 | 0.0025 | 0.0004 | 0.0012 | 0.0033 | 0.0012 | 0.0011 | 0.004 | 0.0003 | 0.0008 | 0.0028 | 0.0011 | 0.0006 |
Sequencing Data
| R1 | R2 | |||||||||
|---|---|---|---|---|---|---|---|---|---|---|
| G1 Post-START | S/G2 | Metaphase | Anaphase | Telophase | G1 Post-START | S/G2 | Metaphase | Anaphase | Telophase | |
| Gene Expression | 12.7108 | 14.989 | 16.5044 | 19.7533 | 16.1295 | 15.677 | 16.9887 | 20.1278 | 17.3961 | 18.5765 |
| Translational Efficiency | 0.6332 | 0.569 | 0.5552 | 0.4613 | 0.4892 | 0.4925 | 0.5281 | 0.3844 | 0.5269 | 0.4838 |
Hit Data
| Dataset | Hit |
|---|---|
| Protein Concentration | ✘ |
| Protein Localization | ✘ |
| Gene Expression | ✘ |
| Translational Efficiency | ✘ |
Endocytosis
| Temp | Actin Patch (Sac6-tdTomato) | Cortical Patch (Sla1-GFP) | Late Endosome (Snf7-GFP) | Vacuole (Vph1-GFP) |
|---|---|---|---|---|
| 37℃ | ||||
| RT |
Cell Cycle Omics
CYCLoPs (Oca5-GFP)
| Gene / Allele | Actin Patch (Sac6-tdTomato) | Cortical Patch (Sla1-GFP) | Late Endosome (Snf7-GFP) | Vacuole (Sac6-tdTomato) |
|---|
| Gene | Images |
|---|
| Gene | Images |
|---|
Images are not yet available
Images are not yet available